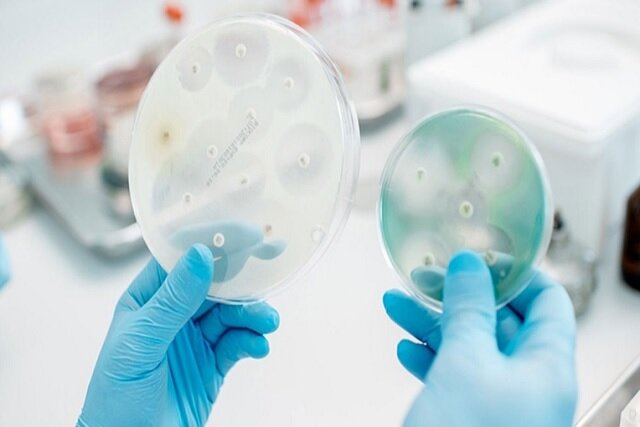

به گزارش ایسنا، عوامل ضد قارچ سنتی اغلب با محدودیتهایی از جمله ایجاد مقاومت و عوارض جانبی مواجه هستند. ظهور فناوری نانو راههای جدیدی را برای سیستمهای دارورسانی باز کرده است و کارایی درمان را افزایش داده است.
در مقالهای که به تازگی محققان در نشریه Nature Communications منتشر کردند، روش ساخت یک سوئیچ فلورسنت فعالشونده با نور را تشریح کردند که میتوان از آن برای مقابله با قارچها استفاده کرد.
این سیستم برای تسهیل انتشار داروهای ضدقارچ با نور بهویژه برای هدف قرار دادن پاتوژن قارچی Rhizoctonia solani طراحی شده است. این تحقیق به محدودیتهای درمانهای ضدقارچ معمولی میپردازد که اغلب از حلالیت ضعیف، تخریب سریع و اثربخشی محدود رنج میبرند.
ترکیبات آزو که به دلیل خواص پاسخگویی به نور خود شناخته میشوند، پس از قرار گرفتن در معرض نور تحت ایزومریزاسیون برگشتپذیر قرار میگیرند که آنها را برای کاربردهای رهایش کنترل شده دارو مناسب میکند. با ادغام ترکیبات آزو در یک چارچوب نانوذرهای، محققان سامانهای ارائه کردند که به طور مؤثر عوامل ضدقارچی را به سایت هدف تحویل میدهد و در عین حال امکان نظارت بر زمان آزادسازی و فعالیت آنها را نیز فراهم میکند. محققان نانوذرات آزو فلورسنت را با استفاده از یک رویکرد سیستماتیک توسعه دادند.
طیفسنجی UV-vis برای نظارت بر تولید ایزومر سیس پس از قرار گرفتن در معرض طول موجهای خاصی از نور انجام شد. اندازهگیریهای تعیین اندازه ذرات با استفاده از دستگاه DLS اطلاعات جالبی در مورد توزیع اندازه و پتانسیل زتا نانوذرات ارائه کرد، در حالی که تصویربرداری TEM امکان ارزیابی مورفولوژی آنها را برای محققان فراهم کرد. برای سنجش خواص ضدقارچی، هر دو آزمایش در شرایط آزمایشگاهی و درون تنی انجام شد.
نتایج نشان داد که نانوذرات آزو فلورسنت فعالیت ضد قارچی قابلتوجهی در برابر Rhizoctonia solani، بهویژه هنگامی که توسط نور فعال میشوند، از خود نشان میدهند. این مطالعه نشان داد که مهار رشد قارچ در نمونههای تیمار شده با نانوذرات در مقایسه با نمونههایی که درمانهای ضدقارچی معمولی دریافت میکنند، بهطور قابل توجهی افزایش یافته است.
به نقل از ستاد نانو، ماهیت پاسخگوی نور نانوذرات باعث آزادسازی کنترل شده ماده فعال PEPA میشود که از طریق تصویربرداری فلورسانس، حضور این ماده تایید شد. توانایی نظارت بر انتشار در زمان واقعی، دیدگاههای ارزشمندی در مورد پویایی عملکرد ضدقارچی این فناوری ارائه میدهد.
این تحقیق پیشرفتی در درمانهای ضدقارچی از طریق ایجاد یک سوئیچ آزو فلورسنت فعال شده با نور مرئی ارائه میکند.
انتهای پیام